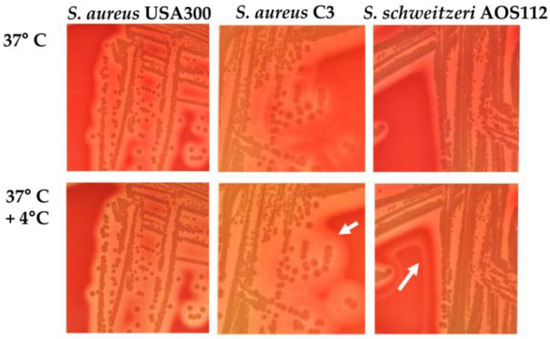
Microorganisms 10 00770 g001

Abstract
The Staphylococcus aureus-related complex is formed by the Staphylococcus aureus, Staphylococcus schweitzeri, Staphylococcus argenteus, Staphylococcus roterodami and Staphylococcus singaporensis. Within this complex, S. schweitzeri is the only species mainly found in African wildlife, but it is rarely detected as a colonizer in humans or as a contaminant of fomites. The few detections in humans are most likely spillover events after contact with wildlife. However, since S. schweitzeri can be misidentified as S. aureus using culture-based routine techniques, it is likely that S. schweitzeri is under-reported in humans. The low number of isolates in humans, though, is consistent with the fact that the pathogen has typical animal adaptation characteristics (e.g., growth kinetics, lack of immune evasion cluster and antimicrobial resistance); however, evidence from selected in vitro assays (e.g., host cell invasion, cell activation, cytotoxicity) indicate that S. schweitzeri might be as virulent as S. aureus. In this case, contact with animals colonized with S. schweitzeri could constitute a risk for zoonotic infections. With respect to antimicrobial resistance, all described isolates were found to be susceptible to all antibiotics tested, and so far no data on the development of spontaneous resistance or the acquisition of resistance genes such the mecA/mecC cassette are available. In summary, general knowledge about this pathogen, specifically on the potential threat it may incur to human and animal health, is still very poor. In this review article, we compile the present state of scientific research, and identify the knowledge gaps that need to be filled in order to reliably assess S. schweitzeri as an organism with global One Health implications.
1. Introduction
The One Health concept recognizes that the health of humans is closely connected to the health of animals and the environment. Among bacterial pathogens, staphylococci have proven to be appropriate models for “One Health” studies, as certain species and clones can be transmitted from humans to animals (wildlife and farm animals) and vice versa [1]. S. aureus causes high morbidity and high attributable mortality, and is therefore a major threat to public health and an economic burden on health systems worldwide. Infection with S. aureus also poses a major health risk in animals (e.g., bovine mastitis) [2]. Wild animals are potential reservoirs for the transmission of S. aureus. Frequent contact between wild animals and livestock as well as contact with humans increase the transmission of bacteria and enhance the risk of colonization and infection in humans and animals [1].
A few years ago, whole genome sequencing (WGS) revealed that isolates from several specific S. aureus lineages are divergent from classical S. aureus, and they were designated as closely related but separate coagulase-positive species. They have been assigned as S. argenteus and S. schweitzeri [3,4]. Together with S. aureus, these species form the S. aureus complex. Only recently, two more members of the S. aureus complex have been described: S. roterodami and S. singaporensis [5,6]. While S. aureus, S. argenteus, S. roterodami and S. singaporensis have been isolated from human infections, S. schweitzeri has been found almost exclusively as a colonizer of fruit bats and non-human primates in West and Central Africa, but not as a colonizer or cause of infection in humans [3,5,6,7,8,9].
S. schweitzeri is named after Albert Schweitzer, Nobel Peace Prize Laureate and founder of the Hôpital Albert Schweitzer in Lambaréné (in formerly French Equatorial Africa, today Gabon) [4].
The bacterium can easily be mistaken for another species of the S. aureus complex using culture-based routine techniques. For this reason, colonization or even infection in humans or domestic animals by S. schweitzeri might have gone unreported. Since it produces pathogenic factors such as enterotoxins, toxic shock syndrome toxins, exfoliative toxins, hemolysins, adhesins and autolysins [3,8,9,10], it is conceivable that S. schweitzeri has the ability to cause infections in humans.
Given the possible transmission of S. schweitzeri from wildlife to humans or livestock, and the possible adaptation of this bacterium to humans, it is important to understand the physiology of this potential One Health pathogen and to develop conventional identification methods to better assess its prevalence. This review aims to summarize existing information on S. schweitzeri and to identify knowledge gaps.
2. The S. aureus Complex
S. aureus, S. schweitzeri, S. argenteus, S. roterodami and S. singarporensis form the S. aureus complex [3,4,5,6]. The members of the S. aureus complex other than S. schweitzeri will be briefly introduced here.
S. aureus is a globally occurring human commensal, as well as a pathogen in humans and animals [11,12,13]. Infections caused by S. aureus are of particular concern due the virulence of the pathogen, as well as to the frequent occurrence of antimicrobial (multi) resistance [14]. Given the wealth of literature on S. aureus, any more detailed discussion here is precluded for the sake of the review format of this article.
S. argenteus was originally described as a community-acquired (CA) methicillin-resistant S. aureus (MRSA) lineage belonging to the clonal complex (CC) CC75. The first isolates were recovered from patients with CA-MRSA infections in Australian Aboriginal communities [15]. Subsequently, the complex was delineated as S. argenteus [4]. In the meantime, S. argenteus has been found worldwide, e.g., in Thailand, Japan, France, Belgium, Trinidad, Tobago and Africa, both in humans and animals; however this species seems to be predominantly associated with humans [3,8,16,17,18,19,20,21,22,23]. S. argenteus and S. aureus differ in the amino acid sequence contained in peptidoglycan, while S. argenteus and S. schweitzeri possess the same peptidoglycan type [4]. At the molecular level, the nucleotide sequences of S. argenteus display 87.4% identity with S. aureus [24]. The pathogenicity of S. argenteus appears to be comparable to that of S. aureus, and 76.6% of the virulence genes of S. aureus have also been found in S. argenteus [24]. Some isolates also produce Panton–Valentine leukocidin (PVL) [15,25], a toxin associated with S. aureus isolates causing skin and soft tissue infections [26,27]. The absence of the pigment staphyloxanthin in S. argenteus results in the whitish color of the colonies [4,28]. Many S. argenteus isolates are penicillin-resistant [17], while other antibiotic resistances are less frequent; for instance, methicillin-resistance was found in isolates from Australia or Denmark [15,29].
S. roterodami was first described in 2021 by Schutte et al. [6]. This species was isolated from a human foot wound infection in the Netherlands. However, the patient probably became infected with S. roterodami in Bali after suffering an injury to his foot. To our knowledge, there is only this one isolate described so far. The strain was originally identified as S. argenteus. Antimicrobial susceptibility was determined using the Vitek 2 susceptibility testing card for Gram-positive bacteria, and S. roterodami was found to be susceptible to all antibiotics tested. An analysis of cellular fatty acids showed several differences in fatty acid proportions compared to S. aureus, S. argenteus and S. schweitzeri [6].
In 2021, S. singaporensis was described by Chew et al. following a retrospective clinical laboratory cohort study of non-S. aureus complex members in Singapore [5]. Six out of forty-three isolates stood out as genetically distinct from S. argenteus. S. singaporensis was found in infectious diseases in humans, and the clinical features of these infections were similar to S. aureus infections. The isolates did not contain some of the virulence genes typically associated with S. aureus, i.e., staphylococcal enterotoxins, tst (toxic shock syndrome Toxin-1), or pvl (Panton–Valentine leukocidin). The S. singaporensis isolates did not reveal antibiotic resistance [5].
3. Prevalence of S. schweitzeri
To date, S. schweitzeri isolates have only been reported from sub-Saharan Africa, namely Gabon, Nigeria, DR Congo and Côte d’Ivoire (Table 1). The isolates were obtained almost exclusively from animals, fruit bats, non-human primates and a gorilla. In three cases, colonization in humans was detected, but these were probably spillover events from handling animals that carried S. schweitzeri [3,10,30]. This low rate was actually surprising, because S. schweitzeri has been found in animals that serve as bushmeat [9]. Infections caused by S. schweitzeri have not yet been reported. Livestock colonized or infected with S. schweitzeri, such as goats or cattle, have also not yet been found in a large multi-center study [9].

Table 1.
Prevalence of Staphylococcus schweitzeri in humans and animals.
Table 1.
Prevalence of Staphylococcus schweitzeri in humans and animals.
| Source | Prevalence (n/Total n (%)) | Country | Year | Setting | Antimicrobial Resistance | Ref. |
|---|---|---|---|---|---|---|
| Fomites | 2/239 (0.8%) | Nigeria | 2015–2016 | Contamination | None detected | [31] |
| Fruit bat (Eidolon helvum) | 11/250 (4.4%) | Nigeria | 2015–2016 | Fecal colonization | None detected | [8] |
| Fruit bat (Rousettus aegyptiacus) | 2/55 (4%) | Gabon | 2015 | Colonization | None detected | [32] |
| Human | 1/500 (0.2%) | Gabon | 2009 | Colonization | None detected | [33] |
| Human | 2/1014 (0.2%) | Gabon | 2012–2013 | Colonization | Not stated | [30] |
| Monkeys | 1/12 (8%) | Côte d’Ivoire | 2012 | Colonization | None detected | [9] |
| Monkeys | 17/71 (24%) | Gabon | 2010–2013 | Colonization | None detected | [9] |
| Monkeys | 6/10 (60%) | DR Congo | 2011 | Colonization | None detected | [9] |
| Wildlife | 0/2855 (0%) | Austria, Germany, Sweden | Not stated | Colonization and infection | Not applicable since no S. schweitzeri was found | [34] |
Important information: S. schweitzeri isolates originally identified as S. aureus by Ngoa et al., 2012 [33] are also included in this table.
4. Identification
Identification by routine methods (e.g., catalase, coagulase, MALDI-TOF) is challenging, as these diagnostic approaches cannot yet delineate the species of the S. aureus-related complex reliably, and it is likely that S. schweitzeri remains unnoticed in routine settings, particularly in low-resource settings where genomic surveillance is not in place. Although S. schweitzeri is included in MALDI-TOF databases (e.g., MBT Compass IVD software, version 4.2.90, Bruker, Bremen), the current profiles do not reliably distinguish between S. schweitzeri and other members of the S. aureus-related complex (this is our own observation). Suspicious signs that point towards S. schweitzeri are: (i) isolates detected in animals (bats, monkeys) or humans with close contact to these animals; (ii) double hemolytic zones on blood agar (Figure 1); and (iii) the absence of any antimicrobial resistance. However, definite species confirmation requires genetic analyses.
Figure 1.
Hemolysis of Staphylococcus aureus USA300, S. aureus C3, and Staphylococcus schweitzeri AOS112. Cultivation on Columbia blood agar at 37 °C overnight, followed by cooling to 4 °C for 24 h results in an enhanced hemolysis pattern plates only with S. aureus C3 (animal adapted goat isolate with intact hlb gene [35]) and S. schweitzeri AOS112 [31] (arrows indicate double hemolysis) but not with the human-adapted S. aureus USA300 [36] (digital photos for this review article were taken after incubation at 37 °C and after further incubation at 4 °C).
4.1. PCR
A thermostable nuclease (Nuc1) is part of the core genome of S. aureus (i.e., present in almost all S. aureus isolates). S. schweitzeri possess a divergent thermostable nuclease, and the encoding gene (nucM) cannot be amplified by the primers proposed by Brakstad et al. [37] for the confirmation of S. aureus due to mismatches (2 of 21 nucleotides and 5 of 24 nucleotides) at the two primer binding sites [37]. Thus, using the PCR by Brakstad et al., S. schweitzeri is nuc-negative, while S. aureus and S. argenteus are nuc-positive.
In addition, Zhang et al. proposed a PCR targeting the nonribosomal peptide synthetase (NRPS) gene to distinguish S. aureus from S. schweitzeri and S. argenteus based on the length of the amplificate (S. aureus: 160 bp; S. schweitzeri and S. argenteus: 340 bp) [38].
While the results of nuc and NRPS PCR already allow a good differentiation between S. schweitzeri and S. argenteus (and S. aureus), high similarities are a reason for confusion with S. roterodami/S. singaporensis species, and necessitate sequencing methods for definitive identification (Supplementary Figure S1).
4.2. Sequencing
Several sequence-based genotyping methods are available to confirm the species of S. schweitzeri. Although spa typing gives a hint towards S. schweitzeri, this method can be ambiguous even in spa types typical of S. schweitzeri because spa typing and multilocus sequence typing are discordant in 10% of isolates (assessed in an American collection of S. aureus) [39].
Recent studies applied multilocus sequence typing (MLST) or whole genome sequencing to distinguish the members of the S. aureus-related complex [5,6,10,31]. Phylogenetic trees are constructed to identify the closest related species within the S. aureus complex. This implies that the respective candidate species are included in the queried database. For correct species identification, a standard set of type strains of S. schweitzeri (FSA084T = DSM 28300T = SSI 89.004T), S. argenteus (MSHR1132T = DSM 28299T = SSI 89.005T), S. roterodami (DSM111914T = JCM34415T), S. singaporensis (SS21T = DSM 111408T = NCTC14419T) and S. aureus (DSM20231T = ATCC12600T) should be included in any phylogenetic tree for species delineation [4,5,6].
The concatenated sequences of the alleles of the seven housekeeping genes in the S. aureus MLST typing scheme reliably delineate species-specific clusters in a Neighbor-Joining tree (Figure 2). Such a delineation in different species-related clades holds true for other phylogenetic methods (e.g., maximum likelihood method, Supplementary Figure S2). Similarly, the core genome MLST (cgMLST) for S. aureus including 1861 targets can be used to construct phylogenetic trees with a higher resolution [10].

Figure 2.
Phylogeny of Staphylococcus schweitzeri. The concatenated sequences of the seven alleles included in the multilocus sequence typing (MLST) scheme were used to construct a Neighbor-Joining tree for this review. The sequences were obtained from the PubMLST database (https://pubmlst.org/, accessed on 30 November 2021). The tree is rooted to the S. aureus sequence types (ST) ST5, ST22, ST30, ST45 and ST398 (collapsed). S. argenteus STs (collapsed) and S. roterodami/S. singaporensis ST were used as published elsewhere [3,5,6]. Only bootstrap values ≥ 80% were displayed.
Sequencing of the 16s RNA gene can be used to delineate S. schweitzeri from other members of the S. aureus-related complex, despite only a few polymorphisms (Figure 3) [40]. However, discriminatory power might not be sufficient if only partial sequences of the 16s RNA gene are used. The sequencing of nuc was suggested by Schutte et al. to discriminate S. roterodami from S. schweitzeri [6]. However, due to the variance of nuc in S. schweitzeri, this approach appears inappropriate as S. roterodami and S. schweitzeri are located in the same cluster (Figure 3a). Whether a correct discrimination of the members of the S. aureus complex is possible via sequencing of the 16s RNA gene or nuc still needs to be investigated in more detail.

Figure 3.
(a) Sequence-based identification of Staphylococcus schweitzeri. Neighbor-Joining trees were constructed for this review using (a) the complete sequences of the thermostable nuclease gene (nuc) and (b) the 16s RNA gene of members of the S. aureus complex. Sequences were obtained from GenBank (nuc: KJ748637 to KJ748639, OE998560.1, SA0746, SA1160, SAV0815, Sca_0025, SSP1444, SE100 and 16s RNA gene: P011526.1, MF678863.1, OD916897.1, MT628672, MT628673, MT628669, MT628670, MT628671, MT628674, NR_118997.2, CCEK01000031.1, CCEL01000025.1).
Therefore, to reliably identify S. schweitzeri, we suggest two screening steps by PCR (nuc and NRPS) and a confirmation either by MLST or WGS (Figure 4).

Figure 4.
A proposed algorithm for the species identification of Staphylococcus schweitzeri. Colonies provisionally identified as “Staphylococcus aureus” should be further analyzed if they are from African wildlife and if the colonies have double hemolytic zones and do not show antimicrobial resistance. A two-step PCR approach (NRSP-PCR, nuc-PCR) should be followed by genome sequencing for ultimate species confirmation. There are hints that S. roterodami and S. singaporensis might be negative in the nuc-PCR by Brakstad et al. [37].
5. Antibiotic Resistance
All S. schweitzeri isolates found so far were susceptible to all antimicrobial agents tested, and no methicillin-resistant isolates have been reported yet (Table 1). Only in one study was no information given regarding the antimicrobial resistance of S. schweitzeri. [30]. Antimicrobial susceptibility testing was conducted in almost all studies using Vitek2 automated test systems (bioMérieux, Marcy l’Etoile, France), and by applying European Committee on Antimicrobial Susceptibility Testing (EUCAST) clinical breakpoints [8,9,31,32]. In one study, isolates were subjected to antimicrobial susceptibility testing using the disc diffusion method according to Clinical and Laboratory Standards Institute (CLSI) [33]. Whether S. schweitzeri is able to produce beta-lactamases on exposure to beta-lactam antibiotics, or whether it can even become methicillin-resistant by acquiring the staphylococcal cassette chromosome mecA/mecC from S. aureus is not known and still needs to be elucidated.
6. Pathogenicity
Although no clinical infections with S. schweitzeri have been detected yet, it has been shown in vitro that S. schweitzeri has many of the pathogenicity factors already known from S. aureus. Of 111 virulence genes of S. aureus examined, 86 (77.5%) were also found in S. schweitzeri. It has been discussed that the pan-genome of these bacteria contains all virulence genes necessary for the pathogenicity of S. aureus [24].
S. schweitzeri belongs to the coagulase-positive staphylococci and most isolates are able to coagulate human, rabbit, canine and equine plasma, but not porcine or avian plasma [10,41]. Capsular polysaccharides (CP) are virulence factors that can protect the pathogen to evade opsonophagocytic killing [42]. Many S. schweitzeri isolates contain the cap5 gene encoding for CP type 5, and only few contain genes encoding for CP type 8 [10,24]. In contrast, African S. aureus isolates from humans as well as from non-human primates were shown to contain the genes for CP5 and CP8, either equally distributed (non-human primates) or biased towards CP8 (humans) [43,44,45]. Many S. schweitzeri isolates are positive for the edinB (epidermal cell differentiation inhibitor) gene in combination with the exfoliative toxin D (etd) [10]. EDIN catalyze the inactivation of RhoA, a regulator of the host cell actin cytoskeleton, while ETD is a serine protease [46,47]. Other protease genes found in the genome of S. schweitzeri are sspA and sspP, but not aur or sspB [10].
The pathogen is capable of forming a biofilm in vitro [10]. Numerous virulence factors regulate biofilm formation such as the thermostable nuclease Nuc. The primary structures of Nuc from S. schweitzeri (NucM) and S. aureus (Nuc1) were found to be different (identity 78.1–80.4%, similarity 92.4–94.1%, Figure 3); however, the nuclease activities were identical, as well as the biofilm formation [10,40]. In experiments, the ability of S. schweitzeri to form biofilms was significantly lower than that of S. epidermidis, which may be related to the fact that the genome of S. schweitzeri harbors the genes icaC and icaD, which are important for biofilm formation, but neither bap nor icaA [10].
The S. schweitzeri genome can contain enterotoxin genes such as seb, seg, seh, sei, sel, sen and the toxic shock toxin (tst) gene. For alpha-toxin (Hla), a membrane-damaging toxin that can lead to cell permeability and induce cell necrosis, higher released Hla protein levels were detected in S. schweitzeri than in S. aureus [48]. We demonstrated a cell-destructive efficacy of S. schweitzeri supernatant on A549 cells, a human alveolar epithelial cell line, and on Vero cells, a kidney epithelial cell line derived from an African green monkey, comparable to that of S. aureus [10]. This cytotoxic effect might also be attributable to alpha-toxin.
Traditionally, S. aureus has been considered a pyogenic extracellular pathogen, but S. aureus can also be taken up into host cells, such as epithelial and endothelial cells [36]. In this process, S. aureus binds to the α5β1-integrin of the host cell via a fibronectin bridge with the help of the fibronectin-binding proteins (FnBPs). This leads to integrin clustering, the initiation of intracellular signaling cascades, and finally reorganization of the actin cytoskeleton and S. aureus uptake into the host cell [49]. The adhesins FnBPA and FnBPB, which are important for the binding of S. aureus to fibronectin and thus also for uptake into host cells, are also present in S. schweitzeri. In line with this, S. schweitzeri can be taken up by epithelial cells in the same way as S. aureus [10]. The invasion of non-professional phagocytes is followed by the activation of the host cells, leading e.g., to an increase in cytokine production. In addition, many S. aureus isolates are able to translocate from the phagolysosomes into the cytoplasm, similarly to S. schweitzeri [10,50]. This phagolysosomal escape is a prerequisite for the bacteria to kill the host cells from the inside [51,52]. Escaping into the cytoplasm as well as intracellular cytotoxicity has also been shown for S. schweitzeri isolates [10]. In addition to the adhesins FnBPA and FnBPB, S. schweitzeri harbors genes for the adhesin clumping factors A and B (ClfA, ClfB), collagen-binding adhesin CNA, extracellular matrix binding protein Ebh, elastin binding protein Ebp, and the extracellular fibrinogen-binding protein Efb [10,24]. The absence of map (eap) in the genome of S. schweitzeri is striking. Interestingly, only fragments and not the complete map gene were detected in African S. aureus isolates [10,53].
During infection bacteria need iron which can be obtained from the blood. S. aureus uses a hemoglobin receptor, IsdB, to bind to hemoglobin and to steal iron-containing heme. IsdB from S. schweitzeri has only 77% similarity to S. aureus; however, it binds hemoglobin from primates with a similar pattern of species preference as S. aureus [54].
In summary, these results show that S. schweitzeri shares many virulence features with S. aureus.
7. Animal Adaption
While many S. schweitzeri characteristics suggest a possible transfer of the pathogen from animals to humans, the pathogen also shows characteristics that suggest an adaptation to its animal hosts. For instance, S. schweitzeri seems to grow better than S. aureus at 34 °C and 40 °C, which correspond to the respective body temperatures of bats and monkeys [10].
Adaptation to a new host such as humans would require S. schweitzeri to overcome the host’s immune defenses, such as T-cell-mediated immunity, the complement system, neutrophils, and phagocytes. In S. aureus, the acquisition and loss of mobile genetic elements (MGEs) often leads to host-specific adaptation. Sa3int phages, which are integrated into the hlb locus-encoding beta-hemolysin (Hlb), have a special role in this process. These phages carry the scn, chp, and sak genes, encoding the human-specific immune evasion factors staphylococcal complement inhibitor, and chemotaxis inhibitory protein and plasminogen activator staphylokinase, respectively [55,56]. Up to 96% of human S. aureus nasal isolates carry the Sa3int phages; these isolates typically have a truncated hlb and are thus unable to produce Hlb as visible by the absence of double hemolytic zones [55] (Figure 1). The transfer of human-adapted isolates to livestock is accompanied by the loss of Sa3int phages. Monkey-adapted S. aureus also lack the immune evasion factors [57]. The same was shown for S. schweitzeri, and the hlb gene was found to be intact [10]. However, S. schweitzeri possesses in its genome the integrase groups φ1–3, indicating the presence of the prophages [24]. Whether S. schweitzeri can also integrate Sa3int phages has not yet been investigated.
The bi-component leukotoxin PVL is also phage-encoded. In sub-Saharan Africa, about half of the S. aureus isolates from humans are PVL-positive, whereas in Germany PVL is almost absent [53]. PVL has a high species specificity, targets the human C5a receptor, and therefore attacks only human neutrophils. It has no cytolytic effect, e.g., on Java monkey neutrophils [58]. It is therefore not surprising that PVL has not been found in S. schweitzeri yet [10]. In contrast, a leukocidin LukAB similar to that of S. aureus was also detected in S. schweitzeri. This has a similar high cytotoxic activity with respect to human dendritic cells compared to S. aureus, but the effect on human neutrophils, monocytes and macrophages is reduced [59].
Many bacteria have a defense system against foreign genes, since these can also harm the bacteria. The CRISPR-Cas (clustered regularly interspaced short palindromic repeats and the CRISPR-associated genes (Cas)) system can protect bacterial cells from the integration of foreign genes in their genome. So far, little is known about the role of CRISPR-Cas in S. aureus, and only a few S. aureus seem to bear this system [60]. For S. schweitzeri, this has not yet been investigated.
It has not yet been shown that S. schweitzeri can overcome the human immune system. This could also be the reason why the pathogen has, to date, almost only been detected in animals. So far, it is still questionable whether S. schweitzeri can acquire genes from S. aureus via horizontal gene transfer that allow it to adapt to humans.
8. Knowledge Gaps and Outlook
Our understanding of S. schweitzeri as an emerging One Health pathogen is still poor. Its presence both in animals and humans with a significant imbalance towards wildlife qualifies it as a One Health pathogen. However, despite its virulence in vitro, no infections are reported yet, neither in humans nor in animals. There are still many knowledge gaps to be filled about this bacterium (Table 2). Only a comprehensive knowledge on S. schweitzeri allows us to predict if it might become a relevant pathogen in veterinary and human medicine. If this is the case, close contact with monkeys and bats would be a source of risk for S. schweitzeri infections. In addition, globalization and climate change might further facilitate the worldwide spread of this exceptionally equipped member of the Staphylococcus pathogen group, requiring reliable microbiologic diagnostics and clinical case ascertainment.

Table 2.
Knowledge gaps and suggestions for future research on S. schweitzeri.
Supplementary Materials
The following supporting information can be downloaded at: https://www.mdpi.com/article/10.3390/microorganisms10040770/s1, Figure S1: Alignment of nuc sequences; Figure S2: Phylogenetic tree of members of the Staphylococcus aureus-related complex.
Author Contributions
S.N. and F.S. contributed to the conceptualization and writing of the manuscript; C.A.-K. participated in the writing; A.K.N., J.A.D. and M.H. provided valuable inputs in the preparation of the manuscript; S.N. and F.S. created the illustrations. All authors have read and agreed to the published version of the manuscript.
Funding
This work has been supported by the German Federal Ministry of Education and Research (BMBF) (FKZ 01DG21002). We acknowledge support from the Open Access Publishing Fund of University of Muenster.
Data Availability Statement
Not applicable.
Acknowledgments
We thank A.O. Shittu for providing the isolates S. aureus C3 and S. schweizeri AOS112.
Conflicts of Interest
The authors declare no conflict of interest.
References
- Abdullahi, I.N.; Fernandez-Fernandez, R.; Juarez-Fernandez, G.; Martinez-Alvarez, S.; Eguizabal, P.; Zarazaga, M.; Lozano, C.; Torres, C. Wild Animals Are Reservoirs and Sentinels of Staphylococcus aureus and MRSA Clones: A Problem with “One Health” Concern. Antibiotics 2021, 10, 1556. [Google Scholar] [CrossRef] [PubMed]
- Benic, M.; Macesic, N.; Cvetnic, L.; Habrun, B.; Cvetnic, Z.; Turk, R.; Duricic, D.; Lojkic, M.; Dobranic, V.; Valpotic, H.; et al. Bovine mastitis: A persistent and evolving problem requiring novel approaches for its control—A review. Vet. Arh. 2018, 88, 535–557. [Google Scholar] [CrossRef]
- Becker, K.; Schaumburg, F.; Kearns, A.; Larsen, A.R.; Lindsay, J.A.; Skov, R.L.; Westh, H. Implications of identifying the recently defined members of the Staphylococcus aureus complex S. argenteus and S. schweitzeri: A position paper of members of the ESCMID Study Group for Staphylococci and Staphylococcal Diseases (ESGS). Clin. Microbiol. Infect. 2019, 25, 1064–1070. [Google Scholar] [CrossRef] [PubMed]
- Tong, S.Y.C.; Schaumburg, F.; Ellington, M.J.; Corander, J.; Pichon, B.; Leendertz, F.; Bentley, S.D.; Parkhill, J.; Holt, D.C.; Peters, G.; et al. Novel staphylococcal species that form part of a Staphylococcus aureus-related complex: The non-pigmented Staphylococcus argenteus sp. nov. and the non-human primate-associated Staphylococcus schweitzeri sp. nov. Int. J. Syst. Evol. Microbiol. 2015, 65, 15–22. [Google Scholar] [CrossRef] [PubMed]
- Chew, K.L.; Octavia, S.; Lai, D.; Lin, R.T.P.; Teo, J.W.P. Staphylococcus singaporensis sp. nov., a new member of the Staphylococcus aureus complex, isolated from human clinical specimens. Int. J. Syst. Evol. Microbiol. 2021, 71, 005067. [Google Scholar] [CrossRef] [PubMed]
- Schutte, A.H.J.; Strepis, N.; Zandijk, W.H.A.; Bexkens, M.L.; Bode, L.G.M.; Klaassen, C.H.W. Characterization of Staphylococcus roterodami sp. nov., a new species within the Staphylococcus aureus complex isolated from a human foot infection. Int. J. Syst. Evol. Microbiol. 2021, 71, 004996. [Google Scholar] [CrossRef]
- Ng, J.W.; Holt, D.C.; Lilliebridge, R.A.; Stephens, A.J.; Huygens, F.; Tong, S.Y.; Currie, B.J.; Giffard, P.M. Phylogenetically distinct Staphylococcus aureus lineage prevalent among indigenous communities in northern Australia. J. Clin. Microbiol. 2009, 47, 2295–2300. [Google Scholar] [CrossRef]
- Olatimehin, A.; Shittu, A.O.; Onwugamba, F.C.; Mellmann, A.; Becker, K.; Schaumburg, F. Staphylococcus aureus Complex in the Straw-Colored Fruit Bat (Eidolon helvum) in Nigeria. Front. Microbiol. 2018, 9, 162. [Google Scholar] [CrossRef]
- Schaumburg, F.; Pauly, M.; Anoh, E.; Mossoun, A.; Wiersma, L.; Schubert, G.; Flammen, A.; Alabi, A.S.; Muyembe-Tamfum, J.J.; Grobusch, M.P.; et al. Staphylococcus aureus complex from animals and humans in three remote African regions. Clin. Microbiol. Infect. 2015, 21, 345-e1. [Google Scholar] [CrossRef] [PubMed]
- Grossmann, A.; Frobose, N.J.; Mellmann, A.; Alabi, A.S.; Schaumburg, F.; Niemann, S. An in vitro study on Staphylococcus schweitzeri virulence. Sci. Rep. 2021, 11, 1157. [Google Scholar] [CrossRef] [PubMed]
- Cheung, G.Y.C.; Bae, J.S.; Otto, M. Pathogenicity and virulence of Staphylococcus aureus. Virulence 2021, 12, 547–569. [Google Scholar] [CrossRef] [PubMed]
- Cvetnic, L.; Samardzija, M.; Duvnjak, S.; Habrun, B.; Cvetnic, M.; Jaki Tkalec, V.; Duricic, D.; Benic, M. Multi Locus Sequence Typing and spa Typing of Staphylococcus aureus Isolated from the Milk of Cows with Subclinical Mastitis in Croatia. Microorganisms 2021, 9, 725. [Google Scholar] [CrossRef] [PubMed]
- Von Eiff, C.; Becker, K.; Machka, K.; Stammer, H.; Peters, G. Nasal carriage as a source of Staphylococcus aureus bacteremia. Study Group. N. Engl. J. Med. 2001, 344, 11–16. [Google Scholar] [CrossRef] [PubMed]
- Guo, Y.; Song, G.; Sun, M.; Wang, J.; Wang, Y. Prevalence and Therapies of Antibiotic-Resistance in Staphylococcus aureus. Front. Cell Infect. Microbiol. 2020, 10, 107. [Google Scholar] [CrossRef] [PubMed]
- McDonald, M.; Dougall, A.; Holt, D.; Huygens, F.; Oppedisano, F.; Giffard, P.M.; Inman-Bamber, J.; Stephens, A.J.; Towers, R.; Carapetis, J.R.; et al. Use of a single-nucleotide polymorphism genotyping system to demonstrate the unique epidemiology of methicillin-resistant Staphylococcus aureus in remote aboriginal communities. J. Clin. Microbiol. 2006, 44, 3720–3727. [Google Scholar] [CrossRef]
- Argudin, M.A.; Dodemont, M.; Vandendriessche, S.; Rottiers, S.; Tribes, C.; Roisin, S.; de Mendonca, R.; Nonhoff, C.; Deplano, A.; Denis, O. Low occurrence of the new species Staphylococcus argenteus in a Staphylococcus aureus collection of human isolates from Belgium. Eur. J. Clin. Microbiol. Infect. Dis. 2016, 35, 1017–1022. [Google Scholar] [CrossRef] [PubMed]
- Chantratita, N.; Wikraiphat, C.; Tandhavanant, S.; Wongsuvan, G.; Ariyaprasert, P.; Suntornsut, P.; Thaipadungpanit, J.; Teerawattanasook, N.; Jutrakul, Y.; Srisurat, N.; et al. Comparison of community-onset Staphylococcus argenteus and Staphylococcus aureus sepsis in Thailand: A prospective multicentre observational study. Clin. Microbiol. Infect. 2016, 22, 458-e11. [Google Scholar] [CrossRef] [PubMed]
- Moradigaravand, D.; Jamrozy, D.; Mostowy, R.; Anderson, A.; Nickerson, E.K.; Thaipadungpanit, J.; Wuthiekanun, V.; Limmathurotsakul, D.; Tandhavanant, S.; Wikraiphat, C.; et al. Evolution of the Staphylococcus argenteus ST2250 Clone in Northeastern Thailand Is Linked with the Acquisition of Livestock-Associated Staphylococcal Genes. MBio 2017, 8, e00802-17. [Google Scholar] [CrossRef] [PubMed]
- Rigaill, J.; Grattard, F.; Grange, S.; Forest, F.; Haddad, E.; Carricajo, A.; Tristan, A.; Laurent, F.; Botelho-Nevers, E.; Verhoeven, P.O. Community-Acquired Staphylococcus argenteus Sequence Type 2250 Bone and Joint Infection, France, 2017. Emerg. Infect. Dis. 2018, 24, 1958–1961. [Google Scholar] [CrossRef]
- Schuster, D.; Rickmeyer, J.; Gajdiss, M.; Thye, T.; Lorenzen, S.; Reif, M.; Josten, M.; Szekat, C.; Melo, L.D.R.; Schmithausen, R.M.; et al. Differentiation of Staphylococcus argenteus (formerly: Staphylococcus aureus clonal complex 75) by mass spectrometry from S. aureus using the first strain isolated from a wild African great ape. Int. J. Med. Microbiol. 2017, 307, 57–63. [Google Scholar] [CrossRef]
- Suzuki, Y.; Kubota, H.; Ono, H.K.; Kobayashi, M.; Murauchi, K.; Kato, R.; Hirai, A.; Sadamasu, K. Food poisoning outbreak in Tokyo, Japan caused by Staphylococcus argenteus. Int. J. Food Microbiol. 2017, 262, 31–37. [Google Scholar] [CrossRef] [PubMed]
- Thaipadungpanit, J.; Amornchai, P.; Nickerson, E.K.; Wongsuvan, G.; Wuthiekanun, V.; Limmathurotsakul, D.; Peacock, S.J. Clinical and molecular epidemiology of Staphylococcus argenteus infections in Thailand. J. Clin. Microbiol. 2015, 53, 1005–1008. [Google Scholar] [CrossRef] [PubMed]
- Monecke, S.; Stieber, B.; Roberts, R.; Akpaka, P.E.; Slickers, P.; Ehricht, R. Population structure of Staphylococcus aureus from Trinidad & Tobago. PLoS ONE 2014, 9, e89120. [Google Scholar] [CrossRef][Green Version]
- Zhang, D.F.; Zhi, X.Y.; Zhang, J.; Paoli, G.C.; Cui, Y.; Shi, C.; Shi, X. Preliminary comparative genomics revealed pathogenic potential and international spread of Staphylococcus argenteus. BMC Genom. 2017, 18, 808. [Google Scholar] [CrossRef]
- Dupieux, C.; Blonde, R.; Bouchiat, C.; Meugnier, H.; Bes, M.; Laurent, S.; Vandenesch, F.; Laurent, F.; Tristan, A. Community-acquired infections due to Staphylococcus argenteus lineage isolates harbouring the Panton-Valentine leucocidin, France, 2014. Eurosurveillance 2015, 20, 21154. [Google Scholar] [CrossRef]
- Lebughe, M.; Phaku, P.; Niemann, S.; Mumba, D.; Peters, G.; Muyembe-Tamfum, J.J.; Mellmann, A.; Strauss, L.; Schaumburg, F. The Impact of the Staphylococcus aureus Virulome on Infection in a Developing Country: A Cohort Study. Front. Microbiol. 2017, 8, 1662. [Google Scholar] [CrossRef]
- Rentinck, M.N.; Kruger, R.; Hoppe, P.A.; Humme, D.; Niebank, M.; Pokrywka, A.; Stegemann, M.; Kola, A.; Hanitsch, L.G.; Leistner, R. Skin infections due to Panton-Valentine leukocidin (PVL)-producing S. aureus-Cost effectiveness of outpatient treatment. PLoS ONE 2021, 16, e0253633. [Google Scholar] [CrossRef]
- Holt, D.C.; Holden, M.T.; Tong, S.Y.; Castillo-Ramirez, S.; Clarke, L.; Quail, M.A.; Currie, B.J.; Parkhill, J.; Bentley, S.D.; Feil, E.J.; et al. A very early-branching Staphylococcus aureus lineage lacking the carotenoid pigment staphyloxanthin. Genome Biol. Evol. 2011, 3, 881–895. [Google Scholar] [CrossRef]
- Hansen, T.A.; Bartels, M.D.; Hogh, S.V.; Dons, L.E.; Pedersen, M.; Jensen, T.G.; Kemp, M.; Skov, M.N.; Gumpert, H.; Worning, P.; et al. Whole Genome Sequencing of Danish Staphylococcus argenteus Reveals a Genetically Diverse Collection with Clear Separation from Staphylococcus aureus. Front. Microbiol. 2017, 8, 1512. [Google Scholar] [CrossRef]
- Okuda, K.V.; Toepfner, N.; Alabi, A.S.; Arnold, B.; Belard, S.; Falke, U.; Menschner, L.; Monecke, S.; Ruppelt-Lorz, A.; Berner, R. Molecular epidemiology of Staphylococcus aureus from Lambarene, Gabon. Eur. J. Clin. Microbiol. Infect. Dis. 2016, 35, 1963–1973. [Google Scholar] [CrossRef]
- Shittu, A.O.; Mellmann, A.; Schaumburg, F. Molecular characterization of Staphylococcus aureus complex from fomites in Nigeria. Infect. Genet. Evol. 2020, 85, 104504. [Google Scholar] [CrossRef]
- Held, J.; Gmeiner, M.; Mordmuller, B.; Matsiegui, P.B.; Schaer, J.; Eckerle, I.; Weber, N.; Matuschewski, K.; Bletz, S.; Schaumburg, F. Bats are rare reservoirs of Staphylococcus aureus complex in Gabon. Infect. Genet. Evol. 2017, 47, 118–120. [Google Scholar] [CrossRef]
- Ngoa, U.A.; Schaumburg, F.; Adegnika, A.A.; Kosters, K.; Moller, T.; Gaus, E.; Fernandes, J.F.; Alabi, A.; Issifou, S.; Becker, K.; et al. Epidemiology and population structure of Staphylococcus aureus in various population groups from a rural and semi urban area in Gabon, Central Africa. Acta Trop. 2012, 124, 42–47. [Google Scholar] [CrossRef]
- Monecke, S.; Gavier-Widen, D.; Hotzel, H.; Peters, M.; Guenther, S.; Lazaris, A.; Loncaric, I.; Muller, E.; Reissig, A.; Ruppelt-Lorz, A.; et al. Diversity of Staphylococcus aureus Isolates in European Wildlife. PLoS ONE 2016, 11, e0168433. [Google Scholar] [CrossRef]
- Shittu, A.O.; Taiwo, F.F.; Frobose, N.J.; Schwartbeck, B.; Niemann, S.; Mellmann, A.; Schaumburg, F. Genomic analysis of Staphylococcus aureus from the West African Dwarf (WAD) goat in Nigeria. Antimicrob. Resist. Infect. Control 2021, 10, 122. [Google Scholar] [CrossRef]
- Strobel, M.; Pfortner, H.; Tuchscherr, L.; Volker, U.; Schmidt, F.; Kramko, N.; Schnittler, H.J.; Fraunholz, M.J.; Loffler, B.; Peters, G.; et al. Post-invasion events after infection with Staphylococcus aureus are strongly dependent on both the host cell type and the infecting S. aureus strain. Clin. Microbiol. Infect. 2016, 22, 799–809. [Google Scholar] [CrossRef]
- Brakstad, O.G.; Aasbakk, K.; Maeland, J.A. Detection of Staphylococcus aureus by polymerase chain reaction amplification of the nuc gene. J. Clin. Microbiol. 1992, 30, 1654–1660. [Google Scholar] [CrossRef]
- Zhang, D.F.; Xu, X.; Song, Q.; Bai, Y.; Zhang, Y.; Song, M.; Shi, C.; Shi, X. Identification of Staphylococcus argenteus in Eastern China based on a nonribosomal peptide synthetase (NRPS) gene. Future Microbiol. 2016, 11, 1113–1121. [Google Scholar] [CrossRef]
- O’Hara, F.P.; Suaya, J.A.; Ray, G.T.; Baxter, R.; Brown, M.L.; Mera, R.M.; Close, N.M.; Thomas, E.; Amrine-Madsen, H. spa Typing and Multilocus Sequence Typing Show Comparable Performance in a Macroepidemiologic Study of Staphylococcus aureus in the United States. Microb. Drug Resist. 2016, 22, 88–96. [Google Scholar] [CrossRef]
- Schaumburg, F.; Pauly, M.; Schubert, G.; Shittu, A.; Tong, S.; Leendertz, F.; Peters, G.; Becker, K. Characterization of a novel thermostable nuclease homolog (NucM) in a highly divergent Staphylococcus aureus clade. J. Clin. Microbiol. 2014, 52, 4036–4038. [Google Scholar] [CrossRef]
- Pickering, A.C.; Yebra, G.; Gong, X.; Goncheva, M.I.; Wee, B.A.; MacFadyen, A.C.; Muehlbauer, L.F.; Alves, J.; Cartwright, R.A.; Paterson, G.K.; et al. Evolutionary and Functional Analysis of Coagulase Positivity among the Staphylococci. mSphere 2021, 6, e0038121. [Google Scholar] [CrossRef]
- Guidry, A.J.; Oliver, S.P.; Squiggins, K.E.; Erbe, E.F.; Dowlen, H.H.; Hambleton, C.N.; Berning, L.M. Effect of anticapsular antibodies on neutrophil phagocytosis of Staphylococcus aureus. J. Dairy Sci. 1991, 74, 3360–3369. [Google Scholar] [CrossRef]
- Schaumburg, F.; Alabi, A.S.; Kock, R.; Mellmann, A.; Kremsner, P.G.; Boesch, C.; Becker, K.; Leendertz, F.H.; Peters, G. Highly divergent Staphylococcus aureus isolates from African non-human primates. Environ. Microbiol. Rep. 2012, 4, 141–146. [Google Scholar] [CrossRef]
- Schaumburg, F.; Kock, R.; Friedrich, A.W.; Soulanoudjingar, S.; Ngoa, U.A.; von Eiff, C.; Issifou, S.; Kremsner, P.G.; Herrmann, M.; Peters, G.; et al. Population structure of Staphylococcus aureus from remote African Babongo Pygmies. PLoS Negl. Trop. Dis. 2011, 5, e1150. [Google Scholar] [CrossRef]
- Schaumburg, F.; Ngoa, U.A.; Kosters, K.; Kock, R.; Adegnika, A.A.; Kremsner, P.G.; Lell, B.; Peters, G.; Mellmann, A.; Becker, K. Virulence factors and genotypes of Staphylococcus aureus from infection and carriage in Gabon. Clin. Microbiol. Infect. 2011, 17, 1507–1513. [Google Scholar] [CrossRef]
- Boyer, L.; Doye, A.; Rolando, M.; Flatau, G.; Munro, P.; Gounon, P.; Clement, R.; Pulcini, C.; Popoff, M.R.; Mettouchi, A.; et al. Induction of transient macroapertures in endothelial cells through RhoA inhibition by Staphylococcus aureus factors. J. Cell Biol. 2006, 173, 809–819. [Google Scholar] [CrossRef]
- Mariutti, R.B.; Souza, T.A.; Ullah, A.; Caruso, I.P.; de Moraes, F.R.; Zanphorlin, L.M.; Tartaglia, N.R.; Seyffert, N.; Azevedo, V.A.; Le Loir, Y.; et al. Crystal structure of Staphylococcus aureus exfoliative toxin D-like protein: Structural basis for the high specificity of exfoliative toxins. Biochem. Biophys. Res. Commun. 2015, 467, 171–177. [Google Scholar] [CrossRef] [PubMed]
- Johansson, C.; Rautelin, H.; Kaden, R. Staphylococcus argenteus and Staphylococcus schweitzeri are cytotoxic to human cells in vitro due to high expression of alpha-hemolysin Hla. Virulence 2019, 10, 502–510. [Google Scholar] [CrossRef] [PubMed]
- Schwarz-Linek, U.; Hook, M.; Potts, J.R. The molecular basis of fibronectin-mediated bacterial adherence to host cells. Mol. Microbiol. 2004, 52, 631–641. [Google Scholar] [CrossRef] [PubMed]
- Fraunholz, M.; Sinha, B. Intracellular Staphylococcus aureus: Live-in and let die. Front. Cell Infect. Microbiol. 2012, 2, 43. [Google Scholar] [CrossRef] [PubMed]
- Moldovan, A.; Fraunholz, M.J. In or out: Phagosomal escape of Staphylococcus aureus. Cell Microbiol. 2019, 21, e12997. [Google Scholar] [CrossRef]
- Stelzner, K.; Boyny, A.; Hertlein, T.; Sroka, A.; Moldovan, A.; Paprotka, K.; Kessie, D.; Mehling, H.; Potempa, J.; Ohlsen, K.; et al. Intracellular Staphylococcus aureus employs the cysteine protease staphopain A to induce host cell death in epithelial cells. PLoS Pathog. 2021, 17, e1009874. [Google Scholar] [CrossRef] [PubMed]
- Ruffing, U.; Alabi, A.; Kazimoto, T.; Vubil, D.C.; Akulenko, R.; Abdulla, S.; Alonso, P.; Bischoff, M.; Germann, A.; Grobusch, M.P.; et al. Community-Associated Staphylococcus aureus from Sub-Saharan Africa and Germany: A Cross-Sectional Geographic Correlation Study. Sci. Rep. 2017, 7, 154. [Google Scholar] [CrossRef] [PubMed]
- Choby, J.E.; Buechi, H.B.; Farrand, A.J.; Skaar, E.P.; Barber, M.F. Molecular Basis for the Evolution of Species-Specific Hemoglobin Capture by Staphylococcus aureus. MBio 2018, 9, e01524-18. [Google Scholar] [CrossRef] [PubMed]
- Rohmer, C.; Wolz, C. The Role of hlb-Converting Bacteriophages in Staphylococcus aureus Host Adaption. Microb. Physiol. 2021, 31, 109–122. [Google Scholar] [CrossRef] [PubMed]
- Van Wamel, W.J.; Rooijakkers, S.H.; Ruyken, M.; van Kessel, K.P.; van Strijp, J.A. The innate immune modulators staphylococcal complement inhibitor and chemotaxis inhibitory protein of Staphylococcus aureus are located on beta-hemolysin-converting bacteriophages. J. Bacteriol. 2006, 188, 1310–1315. [Google Scholar] [CrossRef] [PubMed]
- Senghore, M.; Bayliss, S.C.; Kwambana-Adams, B.A.; Foster-Nyarko, E.; Manneh, J.; Dione, M.; Badji, H.; Ebruke, C.; Doughty, E.L.; Thorpe, H.A.; et al. Transmission of Staphylococcus aureus from Humans to Green Monkeys in The Gambia as Revealed by Whole-Genome Sequencing. Appl. Environ. Microbiol. 2016, 82, 5910–5917. [Google Scholar] [CrossRef]
- Loffler, B.; Hussain, M.; Grundmeier, M.; Bruck, M.; Holzinger, D.; Varga, G.; Roth, J.; Kahl, B.C.; Proctor, R.A.; Peters, G. Staphylococcus aureus panton-valentine leukocidin is a very potent cytotoxic factor for human neutrophils. PLoS Pathog. 2010, 6, e1000715. [Google Scholar] [CrossRef]
- Perelman, S.S.; James, D.B.A.; Boguslawski, K.M.; Nelson, C.W.; Ilmain, J.K.; Zwack, E.E.; Prescott, R.A.; Mohamed, A.; Tam, K.; Chan, R.; et al. Genetic variation of staphylococcal LukAB toxin determines receptor tropism. Nat. Microbiol. 2021, 6, 731–745. [Google Scholar] [CrossRef] [PubMed]
- Cruz-Lopez, E.A.; Rivera, G.; Cruz-Hernandez, M.A.; Martinez-Vazquez, A.V.; Castro-Escarpulli, G.; Flores-Magallon, R.; Vazquez, K.; Cruz-Pulido, W.L.; Bocanegra-Garcia, V. Identification and Characterization of the CRISPR/Cas System in Staphylococcus aureus Strains From Diverse Sources. Front. Microbiol. 2021, 12, 656996. [Google Scholar] [CrossRef] [PubMed]
Publisher’s Note: MDPI stays neutral with regard to jurisdictional claims in published maps and institutional affiliations. |
© 2022 by the authors. Licensee MDPI, Basel, Switzerland. This article is an open access article distributed under the terms and conditions of the Creative Commons Attribution (CC BY) license (https://creativecommons.org/licenses/by/4.0/).